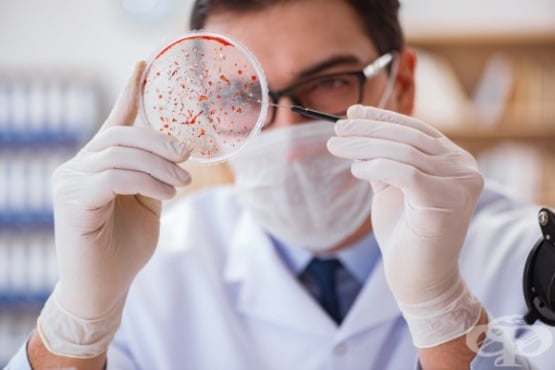

Менингит

- Какво представлява менингитът?
- Какви са видовете менингит и причините за развитието му?
- Рискови фактори за развитие на менингит
- Симптоми и признаци на менингит при бебета, деца и възрастни
- Усложнения при менингит
- Как се поставя диагнозата при менингит?
- Какви са леченията при менингит
- Как да се предпазим от развитие на менингит?
- Възстановяване след менингит
1. Какво представлява менингитът?
Менингитът представлява възпалителен процес, обикновено с остър характер, който ангажира меките обвивки на главния и гръбначния мозък.
Най-честите причини за появата на заболяването са вирусни и бактериални инфекции, а сред най-често засегнатите рискови популации са бебетата, деца и млади хора, имунокомпрометирани пациенти, както и пребиваващи в социални заведения. Честотата на заболяването варира в отделните географски райони, като в някои региони на Африка състоянието показва добре проявена цикличност, довело до създаването на специален термин, а именно менингеален пояс за периода от декември до юни, в който се наблюдава епидемично разрастване на заболелите с менингококов менингит.
Заразяването се осъществява най-често по въздушно-капков път или фекално-орален механизъм, като лошите хигиенни условия допринасят за разпространението на заразата. Менингитът се развива под формата на първично заболяване (с първична локализация мозъчните обвивки) или вторично (при разпространение на болестния процес по кръвен път, по съседство при отит, синузит, черепно-мозъчни травми).
Заболяването протича с характерна симптоматика, включваща най-често синдром на менинго-радикулерно дразнене (вратна ригидност), синдром на повишено вътречерепно налягане (главоболие, гадене, повръщане), огнищни неврологични прояви, общомозъчни и психични увреди.
В зависимост от етиологията се наблюдават някои различия в клиничното протичане и терапевтичния подход, като в някои случаи болестта може да премине без специфична терапия (например при много от вирусните менингити), а в други липсата на лечение крие риск от развитие на животозастрашаващи усложнения (например голяма част от бактериалните менингити).
Диагнозата обикновено се базира на клинико-лабораторните находки, микробиологичното изследване и лумбалната пункция, а терапевтичният подход включва етиологично лечение с подходящи антимикробни препарати, симптоматични средства и общи мероприятия.
Срещу някои от формите на менингит е разработена специфична профилактика с ваксини (пневмококов, менингококов, хемофилен менингит), а общите мерки за предпазване включват добра лична хигиена, поддържане на висока имунна защита, предпазване от инфекции и други.
За оптимално възстановяване от менингит се препоръчва провеждане на подходяща физиотерапия и рехабилитация.
Какви са видовете менингит и причините за развитието му?
Менингитът в зависимост от причинителя бива:
- инфекциозен: вирусен (ентеровируси, херпесни вируси, грипен вирус), бактериален (пневмококи, менингококи, хемофилни бактерии, туберкулозни микобактерии), микотичен (кандидоза, криптококоза), паразитен (амебиаза, цистицеркоза)
- неинфекциозен: алергия към лекарства, след химически отравяния
Според произхода на инфекцията може да бъде първичен (директно засягане на мозъчните обвивки) или вторичен (след хематогенно разпространение или засягане по съседство след прекаран отит, синузит, черепни травми). В зависимост от особеностите на възпалителния процес може да протече като гноен, серозен или асептичен.
Рискови фактори за развитие
Сред водещите рискови фактори за развитие на болестта са:
- имунен дефицит
- пропускане на задължителните имунизации
- посещение и пребиваване в социални заведения
- бременност
- тесен контакт с почва и животни
Изложени на по-висок риск са недоносените новородени, бебета и малки деца, подрастващи, полиморбидни лица в напреднала възраст.
Симптоми и признаци при бебета, деца и възрастни
Заболяването протича идентично при деца над 2 години, подрастващи и възрастни:
- внезапно повишение на телесната температура
- вратна ригидност
- главоболие, съпроводено с гадене
- фотофобия и фонофобия (повишена дразнимост от светлина и звуци)
- повишена раздразнителност
- патологични рефлекси
При менингококов менингит е налице и характерен обрив, който макар и късна изява е изключително типичен за тази форма на заболяването.
При бебета и деца под 2 години заболяването протича с:
- фебрилитет
- повръщане
- изразена сънливост до летаргия
- липса на активност
- трудно задържане в будно състояние
- лошо засукване и липса на апетит
- раздразнителност и по-силен от обичайното плач
- изпъкване (бомбиране) на фонтанелата
Усложнения
Менингитът крие риск от развитие на сериозни, включително и фатални последици, като:
- увреждания на слуховия и зрителния анализатор
- засягане на когнитивните способности
- нарушения в походката, гърчове
- бъбречна недостатъчност
- шоково състояние
- кома, леталитет
Как се поставя диагнозата
Поставянето на диагнозата при менингит изисква комплексен и целенасочен подход, като значение имат данните, получени от:
- разпита на болния и физикалния преглед
- неврологичния статус
- лабораторните и микробиологични изследвания
- лумбална пункция
- образните методи на изследване
Лечение
Терапевтичният подход при менингит се определя в зависимост от етиологията и тежестта на заболяването, наличието на усложнения, индивидуални особености от страна на пациента (възраст, общо състояние, подлежащи заболявания).
Лечението бива:
- етиологично: при изолиране на конкретния причинител се прилагат антибиотици, противовирусни средства, противогъбични средства и други
- симптоматично: включва антипиретици, аналгетици, противовъзпалителни средства, парентерални вливания за корекция на електролитния дисбаланс, мерки за рехидратация на пациента
Как да се предпазим
Профилактиката срещу менингит бива обща и специфична. Общите профилактични мерки включват подобряване на личната и битовата хигиена, повишаване на собствените защитни сили на организма.
Специфичната профилактика е насочена срещу някои форми на бактериален и вирусен менингит и включва приложение на ваксини. Ваксините, включени в задължителния имунизационен календар, предпазващи от развитие на някои по-чести форми на инфекциозен менингит, са пневмококова ваксина, ваксина срещу хемофилус инфлуенце тип Б, БЦЖ ваксина, ваксина морбили, паротит, рубеола, докато ваксините, които могат да се поставят по избор на пациента са противогрипна, менингококова, противоварицелна.
Възстановяване
При някои пациенти се налага назначаване на допълнителни мерки за оптимално и пълно възстановяване след прекаран менингит, като това може да включва физиотерапия и рехабилитация, редовни профилактични прегледи и стриктно наблюдение от страна на близките за поява на слухови и зрителни нарушения, личностови и поведенчески разстройства и други.
Галерия
Библиография
https://en.wikipedia.org/wiki/Meningitis
https://www.mayoclinic.org/diseases-conditions/meningitis/symptoms-causes/syc-20350508
https://www.healthline.com/health/meningitis
https://www.cdc.gov/meningitis/index.html
https://www.webmd.com/children/understanding-meningitis-basics#1
https://medlineplus.gov/meningitis.html
https://kidshealth.org/en/parents/meningitis.html
https://www.childrenshospital.org/conditions-and-treatments/conditions/b/bacterial-meningitis
Изображения: freepik.com

Коментари към Менингит